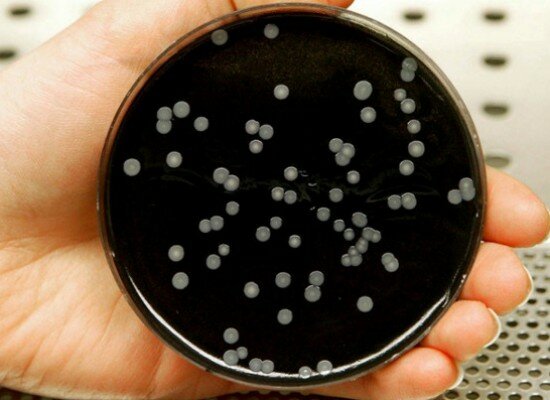
Fábrica de Sines pode reiniciar laboração depois de análises negativas à legionella

O setor do turismo tem vindo a assumir um papel de extrema relevância no desenvolvimento dos países a nível económico e cultural, bem como na difusão dos costumes e línguas dos diferentes povos, tornando-se por isso essencial inovar no setor, dotando os profissionais que atuam na área de competências qualificadas, atualizadas e diferenciadas.
Neste contexto a Escola Superior de Ciências Empresariais do Instituto Politécnico de Setúbal (ESCE/IPS) em parceria com o Instituto Politécnico de Leira (IPL) desenvolveram a Pós-graduação em Gestão e Marketing Turístico, que possibilita aos formandos a aquisição de conhecimentos que aliam a gestão ao marketing turístico, preparando-os para as atuais exigências do mercado de trabalho, bem como para a constante mudança e aumento da competitividade na área do turismo.
A formação ministrada no curso assenta numa base teórica e profissionalizante, em torno de vários temas na área da gestão e do marketing turístico, numa perspetiva integrada de desenvolvimento sustentável, de acordo com os objetivos definidos no Plano Estratégico Nacional de Turismo.
As candidaturas para a Pós-graduação em Gestão e Marketing Turístico decorrem até dia 10 de novembro, devendo ser efetuadas exclusivamente via online no portal da ESCE/IPS em www.esce.ips.pt